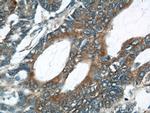
UCP2 Antibody in Immunohistochemistry (Paraffin) (IHC (P))

Search
Proteintech
UCP2 Polyclonal Antibody
{{$productOrderCtrl.translations['antibody.pdp.commerceCard.promotion.promotions']}}
{{$productOrderCtrl.translations['antibody.pdp.commerceCard.promotion.viewpromo']}}
{{$productOrderCtrl.translations['antibody.pdp.commerceCard.promotion.promocode']}}: {{promo.promoCode}} {{promo.promoTitle}} {{promo.promoDescription}}. {{$productOrderCtrl.translations['antibody.pdp.commerceCard.promotion.learnmore']}}

Please note: We are reviewing Western blot images included in the antibody testing data in our catalog, including those provided by third parties. Unless expressly labeled or annotated as “raw-unedited”, Western blot images included in the antibody testing data in our catalog may have been edited, optimized or otherwise adjusted for presentation.
产品信息
11081-1-AP
种属反应
已发表种属
宿主/亚型
分类
类型
抗原
偶联物
形式
浓度
规格
纯化类型
保存液
内含物
保存条件
运输条件
产品详细信息
This antibody detect a band around 28-33 kDa corresponding to UCP2 protein in mouse liver, skeletal muscle and pancreas. Some upper and lower bands also were observed due to the dimer formation and degradation of the UCP2 protein. This antibody was raised against the full-length UCP2 protein and may cross-react with UCP3. It is notable that UCP2 is known to have a very short half-life less than 1 hour. It is strongly recommended that fresh-made lysate be used for western blot assays.
Immunogen sequence: MVGFKATDV PPTATVKFLG AGTAACIADL ITFPLDTAKV RLQIQGESQG PVRATASAQY RGVMGTILTM VRTEGPRSLY NGLVAGLQRQ MSFASVRIGL YDSVKQFYTK GSEHASIGSR LLAGSTTGAL AVAVAQPTDV VKVRFQAQAR AGGGRRYQST VNAYKTIARE EGFRGLWKGT SPNVARNAIV NCAELVTYDL IKDALLKANL MTDDLPCHFT SAFGAGFCTT VIASPVDVVK TRYMNSALGQ YSSAGHCALT MLQKEGPRAF YKGFMPSFLR LGSWNVVMFV TYEQLKRALM AACTSREAPF (1-309 aa encoded by BC011737)
靶标信息
UCPs facilitate the transfer of anions from the inner to the outer mitochondrial membrane and the return transfer of protons from the outer to the inner mitochondrial membrane. They also reduce the mitochondrial membrane potential in mammalian cells. UCP2 gene is expressed in many tissues, with the greatest expression in skeletal muscle. UCP2 is thought to play a role in non shivering thermogenesis, obesity and diabetes.
仅用于科研。不用于诊断过程。未经明确授权不得转售。
生物信息学
蛋白别名: Dicarboxylate carrier UCP2; Mitochondrial uncoupling protein 2; Solute carrier family 25 member 8; UCP 2; UCPH; uncoupling protein; Uncoupling protein 2, mitochondrial
基因别名: Slc25a8; Ucp2
UniProt ID: (Rat) P56500, (Mouse) P70406
Entrez Gene ID: (Rat) 54315, (Mouse) 22228




